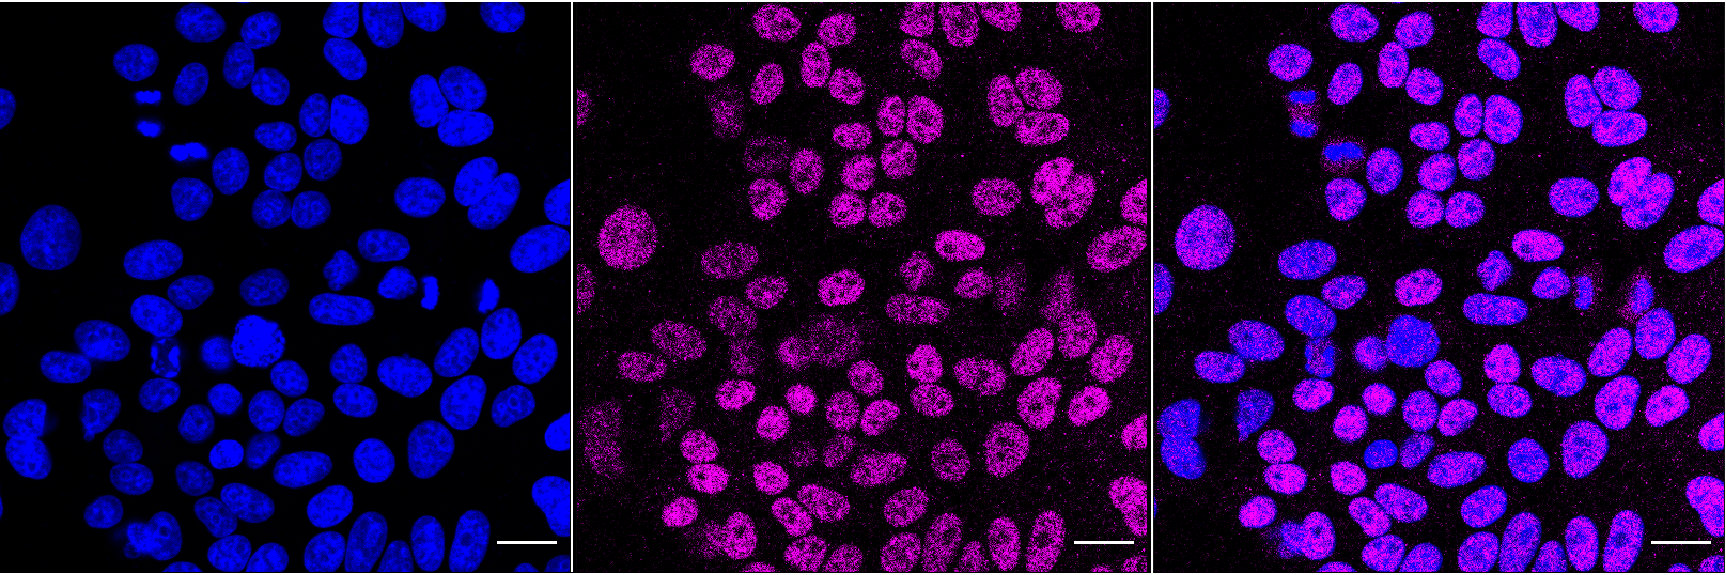

-
中文名稱:FOXA1 Recombinant Monoclonal Antibody
-
貨號:CSB-RA963896A0HU
-
規格:¥1320
-
圖片:
-
Flow cytometric analysis of Forkhead box A1 expression in HepG2 cells using Forkhead box A1 antibody. Green, isotype control; red, Forkhead box A1.
-
Immunocytochemical staining of HepG2 cells with Forkhead box A1 antibody. Nuclei were stained blue with DAPI; Forkhead box A1 was stained magenta with Alexa Fluor? 647. Images were taken using Leica stellaris 5. Protein abundance based on laser Intensity and smart gain: Medium. Scale bar, 20 μm.
-
Western blotting analysis using forkhead box A1 antibody. Total cell lysates (30 μg) from various cell lines were loaded and separated by SDS-PAGE. The blot was incubated with forkhead box A1 antibody and HRP-conjugated goat anti-rabbit secondary antibody respectively.
-
-
其他:
產品詳情
-
Uniprot No.:
-
基因名:
-
別名:FOXA1; Forkhead Box A1; HNF3A; Hepatocyte Nuclear Factor 3-Alpha; Forkhead Box Protein A1; Transcription Factor 3A; HNF-3-Alpha; HNF-3A; TCF-3A; TCF3A; Hepatocyte Nuclear Factor 3, Alpha
-
反應種屬:Human, Rat
-
免疫原:A synthesized peptide derived from Human FOXA1 protein
-
免疫原種屬:Homo sapiens (Human)
-
標記方式:Non-conjugated
-
克隆類型:Monoclonal
-
抗體亞型:Rabbit IgG
-
純化方式:Affinity-chromatography
-
克隆號:24B7
-
濃度:It differs from different batches. Please contact us to confirm it.
-
保存緩沖液:Rabbit IgG in PBS (pH 7.4) containing 50% glycerol, and 0.02% sodium azide.
-
產品提供形式:Liquid
-
應用范圍:ELISA, WB, FC, ICC
-
推薦稀釋比:
Application Recommended Dilution WB 1:1000-1:5000 FC 1:200-1:2000 ICC 1:100-1:1000 -
Protocols:
-
儲存條件:Upon receipt, store at -20°C or -80°C. Avoid repeated freeze.
-
貨期:Basically, we can dispatch the products out in 1-3 working days after receiving your orders. Delivery time maybe differs from different purchasing way or location, please kindly consult your local distributors for specific delivery time.
-
用途:For Research Use Only. Not for use in diagnostic or therapeutic procedures.
相關產品
靶點詳情
-
功能:Transcription factor that is involved in embryonic development, establishment of tissue-specific gene expression and regulation of gene expression in differentiated tissues. Is thought to act as a 'pioneer' factor opening the compacted chromatin for other proteins through interactions with nucleosomal core histones and thereby replacing linker histones at target enhancer and/or promoter sites. Binds DNA with the consensus sequence 5'-[AC]A[AT]T[AG]TT[GT][AG][CT]T[CT]-3'. Proposed to play a role in translating the epigenetic signatures into cell type-specific enhancer-driven transcriptional programs. Its differential recruitment to chromatin is dependent on distribution of histone H3 methylated at 'Lys-5' (H3K4me2) in estrogen-regulated genes. Involved in the development of multiple endoderm-derived organ systems such as liver, pancreas, lung and prostate; FOXA1 and FOXA2 seem to have at least in part redundant roles. Modulates the transcriptional activity of nuclear hormone receptors. Is involved in ESR1-mediated transcription; required for ESR1 binding to the NKX2-1 promoter in breast cancer cells; binds to the RPRM promoter and is required for the estrogen-induced repression of RPRM. Involved in regulation of apoptosis by inhibiting the expression of BCL2. Involved in cell cycle regulation by activating expression of CDKN1B, alone or in conjunction with BRCA1. Originally described as a transcription activator for a number of liver genes such as AFP, albumin, tyrosine aminotransferase, PEPCK, etc. Interacts with the cis-acting regulatory regions of these genes. Involved in glucose homeostasis.
-
基因功能參考文獻:
- High FOXA1 expression is associated with the pathogenesis of gastric cancer. PMID: 30066917
- FoxA1 might be related to the development and differentiation of secretory coil-like structures, as well as the secretory function of the 3D reconstructed eccrine sweat glands. PMID: 29909922
- TUG1 promoted osteosarcoma cell proliferation and suppressed apoptosis by regulating the miR-212-3p/FOXA1 axis. PMID: 29793327
- miR-760 should be considered as a tumor suppressor since it negatively regulates the oncogene protein FOXA1 and regulated TRAIL sensitivity in Non-small cell lung cancer cells. PMID: 29665655
- As a tumor suppressor, FOXA1 targets PIK3R1 directly to inhibit PI3K/Akt signaling pathway, thus exerting a negative regulatory effect on proliferation, migration, and invasion of HCC in male patients. PMID: 29208003
- miR212 suppresses renal cell carcinoma (RCC) proliferation and invasion by modulating FOXA1, suggesting that miR212 may have potential as a therapeutic target in RCC. PMID: 29115609
- the results of the present study suggested that FOXA1 is a potential oncogene in NSCLC PMID: 29115441
- During the ensuing weeks, the PAX2/FOXA1 boundary progressively extended cranially such that by 21 weeks the entire vaginal epithelium was FOXA1-reactive and PAX2-negative. This observation supports Bulmer's proposal that human vaginal epithelium derives solely from urogenital sinus epithelium PMID: 28918284
- The transcription factor FOXA1 directly bound to the PLOD2 promoter, and turned on PLOD2 transcription. In summary, our findings revealed a regulatory mechanism of NSCLC metastasis through EGFR-PI3K/AKT-FOXA1-PLOD2 pathway. PMID: 29072684
- maintenance of the cancer cell state is dependent on recruitment of Mediator and Cohesin through FOXA and master transcription factors PMID: 27739523
- overexpression of GATA3 and FOXA1 cooperate with PPAR activation to drive transdifferentiation of a basal bladder cancer cells to a luminial phenotype. PMID: 27924948
- Results found FOXA1 to be hypermethylated in breast tumors from African American (AA) versus European American (EA) women with ER- cancer, and methylation levels showed strong inverse relationships with both mRNA and protein levels. A significant positive association was identified between parity and FOXA1 methylation in tumors from AA women who did not breastfeed. PMID: 28756535
- High expression of FOXA1 is associated with breast tumor. PMID: 28534958
- High FOXA1 expression was significantly associated with presence of lymph node metastasis (LNM), low tumour-infiltrating lymphocytes (TILs), and submucosal invasion. PMID: 28843920
- Results provide evidence that the atypical expression of FOXA1 transcriptional factor is an important player in psoriasis, as it inhibits maturation of naive T cells into a Treg subpopulation, therefore contributing to the development of psoriatic skin lesions. PMID: 28849568
- Authors demonstrated that ER(alpha), GATA3 and FOXA1 form a transcriptional complex with Ell3 to regulate IL-20 expression in ER(+) breast cancer cells. FOXA1 represses IL-20 expression, whereas GATA3 and ER(alpha) activate it. PMID: 28514748
- the findings show that squamous and micropapillary bladder cancers have different expression patterns of CK14 and FOXA1 and suggest that they arise from distinct precursors. PMID: 28721490
- rs4442975 may not confer a risk of breast cancer occurrence or progression in the Chinese Han population. PMID: 27835577
- As a transcriptionally regulated program, urothelial differentiation operates as a heterarchy, wherein GATA3 is able to co-operate with FOXA1 to drive expression of luminal marker genes, but that P63 has potential to transrepress expression of the same genes. PMID: 28282036
- FOXA1 overexpression mediates endocrine resistance by altering the ER transcriptome and IL-8 expression in ER-positive breast cancer. PMID: 27791031
- Findings suggested FOXA1 may act as an anti-oncogene in gastric cancer (GC) cells. Low-level expression of FOXA1 protein was confirmed in GC tissues and cell lines. FOXA1 over-expression could significantly affect cell proliferation, apoptosis and tumor invasion of GC cells, which may be resulted by reversing EMT. PMID: 29129808
- High expression of FOXA1 is an independent prognostic parameter in ERG negative prostate cancer PMID: 29029032
- A molecular mechanism by which Estradiol antagonizes GR-dependent induction of specific genes by preventing the recruitment of the pioneer factors FOXA1 and FOXA2 in a physiologically relevant model. PMID: 28938408
- Results show that c-Abl phosphorylates FoxA1 at multiple sites. Tyr429 and Tyr464 were identified as the major phosphorylation sites in the FoxA1 C-terminal region. This c-Abl-mediated phosphorylation of FoxA1 promotes the activation of estrogen signaling by inducing its binding to histones. PMID: 27883218
- MLL3 binding was dependent on FOXA1, indicating that FOXA1 recruits MLL3 to chromatin. MLL3 silencing decreased H3K4me1 at enhancer elements but had no appreciable impact on H3K4me3 at enhancer elements. We propose a mechanism whereby the pioneer factor FOXA1 recruits the chromatin modifier MLL3 to facilitate the deposition of H3K4me1 histone marks, subsequently demarcating active enhancer elements PMID: 27926873
- FoxA1 discriminates between medullary thyroid carcinoma and tumors of follicular derivation with sensitivity and specificity greater than calcitonin and carcinoembryonic antigen. PMID: 28546130
- FOXA1 loss may play a significant role in enabling prostate cancer progression to neuroendocrine prostate cancer, whereas IL-8 and MAPK/ERK pathways may be promising targets for therapeutic intervention. PMID: 28319070
- Low FOXA1 expression is associated with breast cancer invasion and metastasis. PMID: 27524420
- the distinct mechanisms by which GATA2 and FOXA1 regulate AR cistrome and suggest that FOXA1 acts upstream of GATA2 and AR in determining hormone-dependent gene expression in prostate cancer. PMID: 26751772
- Study implicates enhancer reprogramming, FOXA1 upregulation, and a retrograde developmental transition in pancreatic ductal adenocarcinoma metastasis. PMID: 28757253
- Studies indicate that microRNA miR-212 exerts its inhibitory effect on hepatocellular carcinoma (HCC) by inhibiting forkhead transcription factor FOXA1 expression. PMID: 27999212
- FOXA1 is expressed by basal cells of squamous epithelium, pre-invasion lesions of the uterine cervix and the head/neck and almost half invasive cervical and head/neck carcinomas, supporting its possible implication in HPV associated carcinomas. PMID: 28209524
- CREB1/FoxA1 signaling is a targetable driver of prostate cancer progression and serves as a biomarker of poor clinical outcomes. PMID: 26743006
- miR-93 may promote the process of epithelial-mesenchymal transition in endometrial carcinoma cells by targeting FOXA1. PMID: 27829043
- conclusion, our results demonstrated that miR24 inhibits breast cancer cells invasion by targeting OGT and reducing FOXA1 stability. These results also indicated that OGT might be a potential target for the diagnosis and therapy of breast cancer metastasis. PMID: 28455227
- FOXA1 is not only able to recognize but also remodel the epigenetic signatures at lineage-specific enhancers, which is mediated, at least in part, by a feed-forward regulatory loop between FOXA1 and TET1. PMID: 27257062
- Based on these results, we suggest that FOXA1 plays a catalytic role in ovarian cancer pathogenesis and development by affecting the expression of the above-mentioned proteins. PMID: 28488543
- these results suggest that FOXA1 suppresses expression of IL6 through inhibition of NF-kappaB recruitment to the IL6 promoter in an ERalpha-independent manner and that reduction in FOXA1 expression induces IL6 expression and contributes to cancer stem cell-like properties in TAM-R cells. PMID: 28270510
- These results suggest a positional-nucleosome-oriented accessing model for Pioneer factors seeking target motifs, in which FOXA1 can examine each underlying DNA nucleotide. PMID: 27458208
- Down-regulation of TRPS1 by miR-373, acting as a transcriptional activator, promotes epithelial-mesenchymal transition (EMT) and metastasis by repressing FOXA1 transcription, expanding upon its previously reported role as a transcription repressor. PMID: 26969828
- FOXA1 is found in ovarian mucinous and Brenner tumours PMID: 28238418
- the results of the present study indicated that FOXA1 may be considered a potential prognostic marker, and may promote tumor growth of CRC by upregulating YAP expression. PMID: 27484093
- meta-analysis showed that high expression of FOXA1 in breast cancer patients was a good prognostic indicator for survival outcome. PMID: 27212698
- FOXA1 promotes cell senescence in EC by interaction with p16INK4a. PMID: 27349269
- There is significantly increased esophageal squamous cell carcinoma risk associated with the FOXA1 rs7144658 T > C polymorphism among male patients. PMID: 27050876
- Meta-analysis results clearly point to an important role of FOXA1 and FOXA2 gene regulatory networks in the etiology of Alzheimer's disease PMID: 26890743
- show that ER and GR both have the ability to alter the genomic distribution of the FoxA1 pioneer factor. Single-molecule tracking experiments reveal a highly dynamic interaction of FoxA1 with chromatin in vivo; FoxA1 factor is not associated with footprints at its binding sites throughout the genome; findings support a model wherein interactions between transcription factors and pioneer factors are highly dynamic. PMID: 27062924
- findings suggest a key role for GalNAc-T4 in the estrogen pathway through FOXA1 glycosylation PMID: 26541755
- The ratio of FoxA1 to FoxA2 in lung adenocarcinoma is regulated by LncRNA HOTAIR and chromatin remodeling factor LSH PMID: 26658322
- Loss of Interdependent Binding by the FoxO1 and FoxA1/A2 Forkhead Transcription Factors Culminates in Perturbation of Active Chromatin Marks and Binding of Transcriptional Regulators at Insulin-sensitive Genes. PMID: 26929406
顯示更多
收起更多
-
亞細胞定位:Nucleus.
-
組織特異性:Highly expressed in prostate and ESR1-positive breast tumors. Overexpressed in esophageal and lung adenocarcinomas.
-
數據庫鏈接:
Most popular with customers
-
-
YWHAB Recombinant Monoclonal Antibody
Applications: ELISA, WB, IHC, IF, FC
Species Reactivity: Human, Mouse, Rat
-
Phospho-YAP1 (S127) Recombinant Monoclonal Antibody
Applications: ELISA, WB, IHC
Species Reactivity: Human
-
-
-
-
-